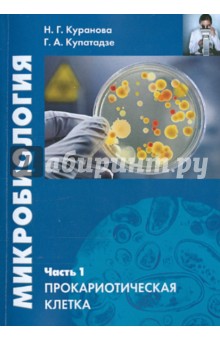
Микробиология. Часть 1. Прокариотическая клетка

Поздравляем! Теперь Вы будете в курсе всех акций!
Хочешь узнавать про акции и скидки первым?
Я согласен с условиями
Пользовательского соглашения